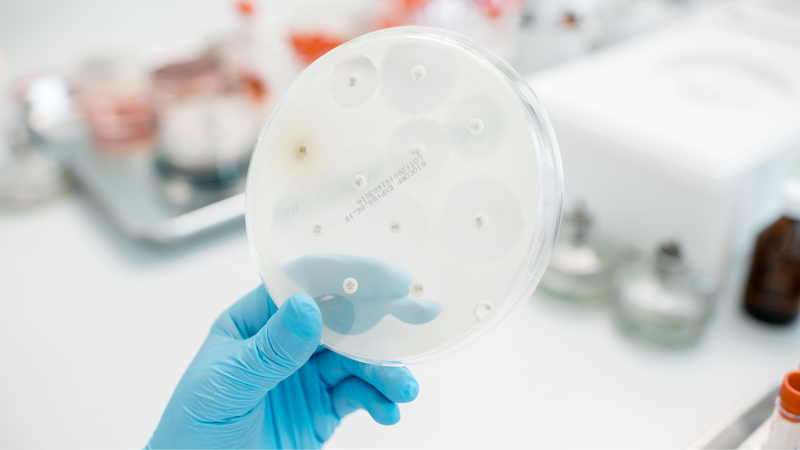
Phối hợp kháng sinh khi nào? 1

Từng làm ở Viện ISDS, nhiều năm cộng tác với CDC Thái Nguyên triển khai dự án phòng chống HIV/AIDS, 2 năm cộng tác với WHO.
Kim Toàn
03/05/2024
Mặc định
Lớn hơn
Trong một vài trường hợp, dùng một loại kháng sinh không thể đẩy lùi được bệnh mà phải cần tới sự phối hợp của hai hoặc ba loại kháng sinh khác nhau. Tuy nhiên không phải lúc nào dùng nhiều loại kháng sinh cũng đúng, việc phối hợp kháng sinh cần được thực hiện theo chỉ định của bác sĩ. Hãy cùng Nhà thuốc Long Châu giải đáp các thắc mắc về phối hợp kháng sinh nhé.
Phối hợp kháng sinh là sử dụng hai hoặc nhiều loại kháng sinh cùng lúc để điều trị nhiễm trùng do vi khuẩn. Việc phối hợp này sẽ mang lại một số lợi ích như: Tăng hiệu quả điều trị, giảm nguy cơ kháng thuốc, điều trị các trường hợp nặng,... Tuy nhiên việc phối hợp kháng sinh cần được thực hiện theo chỉ định của bác sĩ.
Thuốc kháng sinh được sử dụng phổ biến trong điều trị nhiễm khuẩn. Trong thực tế cho thấy, không phải lúc nào dùng một kháng sinh cũng có thể đẩy lùi được bệnh mà cần phải phối hợp nhiều loại thuốc khác nhau.
Vi khuẩn có rất nhiều loại, nó có thể xâm nhập vào cơ thể con người qua nhiều đường khác nhau và gây bệnh ở cùng một cơ quan. Tuy nhiên, không có một loại thuốc nào là đa năng có thể tiêu diệt toàn bộ vi khuẩn cùng một lúc. Mỗi loại có một cơ chế tác dụng riêng biệt với một số loại mầm bệnh. Trong trường hợp này, việc sử dụng phối hợp hai loại kháng sinh cùng lúc, hay thậm chí là nhiều hơn hai, sẽ làm giảm các tác nhân gây bệnh.
Viêm phổi và viêm đường hô hấp nói chung thường do vi khuẩn tụ cầu, liên cầu gây ra, nhưng cũng có thể do vi khuẩn E.coli hoặc Klebsiella gây ra. Kháng sinh nhóm ß-lactam có tác dụng tốt với vi khuẩn tụ cầu, liên cầu, nhưng không có tác dụng với vi khuẩn E.coli hoặc Klebsiella. Aminoglycosid có tác dụng với cả vi khuẩn tụ cầu, liên cầu, E.coli và Klebsiella. Do đó, việc phối hợp kháng sinh nhóm ß-lactam với Aminoglycosid có thể giúp điều trị hiệu quả viêm phổi và viêm đường hô hấp, kể cả khi chưa xác định được vi khuẩn gây bệnh.
Việc phối hợp kháng sinh có thể giúp tăng hiệu quả điều trị, thậm chí là gấp nhiều lần. Một ví dụ điển hình là việc phối hợp giữa kháng sinh Sulfamid với kháng sinh nhóm Trimethoprim:
Khi phối hợp hai thuốc này với nhau, chúng sẽ cùng tác động vào một quá trình, từ đó làm tăng hiệu quả ức chế tổng hợp DNA của vi khuẩn, giúp tiêu diệt vi khuẩn hiệu quả hơn.

Việc phối hợp kháng sinh trên lâm sàng có thể mang lại hiệu quả điều trị cao, nhưng cũng tiềm ẩn nhiều tác hại. Vì mỗi loại kháng sinh đều có tác dụng phụ nhất định, nên khi phối hợp nhiều loại kháng sinh với nhau, tác dụng phụ có thể cộng hưởng, gây ra hậu quả nghiêm trọng cho người bệnh. Ví dụ:
Khi người bệnh sử dụng kết hợp hai nhóm kháng sinh trên thì sẽ phải chịu đựng cả hai tác dụng phụ, và điều đó khiến họ cảm thấy mệt mỏi và khó chịu hơn. Từ đó có thể dẫn đến việc bỏ thuốc, không tuân thủ phác đồ điều trị.
Việc phối hợp kháng sinh có thể gặp phải một số trường hợp phức tạp, chẳng hạn như khi hai loại kháng sinh có cơ chế tác dụng không tương hỗ nhau. Ví dụ, nếu phối hợp Penicillin và Tetracycline để điều trị viêm màng não, thì tác dụng của Tetracycline sẽ bị giảm đi do Penicillin cũng tác động lên riboxom. Do đó, chúng ta cần nắm vững nguyên tắc phối hợp kháng sinh và tránh phối hợp hai loại kháng sinh có thể đối kháng với nhau.

Việc sản xuất kháng sinh hiện nay đã đạt được những bước tiến vượt bậc, với dược tính cao và phổ tác dụng rộng. Do đó, những trường hợp nhiễm khuẩn vừa và nhẹ có thể được điều trị hiệu quả bằng một loại kháng sinh đơn độc. Tuy nhiên, trong những trường hợp nhiễm khuẩn phức tạp hơn, cần cân nhắc sử dụng kháng sinh phối hợp để tăng hiệu quả điều trị và tránh nguy cơ kháng kháng sinh. Ví dụ:
Các ví dụ phối hợp kháng sinh trên lâm sàng:
Viêm phổi nặng: Đối với trường hợp bệnh nhân bị nhiễm khuẩn phổi nặng, việc phối hợp sử dụng 1 kháng sinh nhóm ß-lactam (như Co-amoxiclav, Cefotaxime, Cefuroxime, hay Ceftriaxone...) với 1 kháng sinh Macrolid (như Clarithromycin) được khuyến khích vì hiệu quả diệt khuẩn sẽ được tăng cường.
Sự phối hợp sử dụng kháng sinh nhóm ß-lactam và Macrolid mang lại hiệu quả kép: Diệt trừ các vi khuẩn thông thường gây nhiễm khuẩn đường hô hấp (như Streptococcus pneumoniae, Haemophilus influenzae.) và có tác dụng đối với các vi khuẩn kém điển hình (như Legionella pneumophila, Mycoplasma pneumoniae.).
Nhiễm trùng ổ bụng: Hầu hết các trường hợp nhiễm trùng ổ bụng đều do sự kết hợp của vi khuẩn ái khí và kỵ khí. Do đó, việc sử dụng phối hợp Metronidazole với một kháng sinh phổ rộng như Cefotaxime, Gentamicin hoặc Ciprofloxacin được khuyến khích để tiêu diệt hoàn toàn các tác nhân gây bệnh.
Lưu ý rằng nhiễm trùng ổ bụng, hay chính xác hơn là viêm phúc mạc, là một tình trạng nhiễm trùng nghiêm trọng có thể dẫn đến tử vong nếu không được điều trị kịp thời. Đối với những trường hợp nhiễm trùng nặng như viêm màng trong tim, việc sử dụng đa liệu pháp thường được áp dụng ngay từ đầu.
Viêm màng trong tim: Viêm màng trong tim là một bệnh nhiễm trùng nghiêm trọng, có thể dẫn đến tử vong. Do đó, việc dùng kết hợp kháng sinh cần được chỉ định ngay từ đầu.
Viêm nội tâm mạc: Kháng sinh Penicillin và Gentamicin được phối hợp để điều trị viêm nội tâm mạc do cầu khuẩn đường ruột hoặc tụ cầu khuẩn. Sự kết hợp này đem lại hiệu quả tốt hơn so với chỉ dùng Penicillin.
Điều trị lao: Kết hợp kháng sinh trong điều trị lao giúp giảm tỷ lệ kháng thuốc. Khi dùng riêng Isoniazid thì tỷ lệ kháng thuốc là 1/106, Rifampicin là 1/108. Tuy nhiên, khi kết hợp hai loại này thì tỷ lệ kháng thuốc giảm mạnh. Do đó, phác đồ điều trị lao thường kết hợp 2 - 3 loại kháng sinh khác nhau để đảm bảo hiệu quả và hạn chế nguy cơ kháng thuốc.
Tóm lại, phối hợp kháng sinh là một phương pháp điều trị hiệu quả, nhưng cần được thực hiện đúng cách để hạn chế nguy cơ kháng thuốc. Người bệnh cần tuân thủ đúng phác đồ phối hợp kháng sinh, liều lượng, khoảng cách dùng thuốc và thời gian điều trị theo chỉ định của bác sĩ. Tuyệt đối không tự ý sử dụng hoặc lạm dụng thuốc kháng sinh, vì có thể gây ra nhiều tác dụng phụ nguy hiểm.

Bài viết trên bao gồm các thông tin trả lời cho câu hỏi có nên phối hợp nhiều loại kháng sinh cùng lúc không. Hy vọng qua bài viết giúp bạn hiểu được tác dụng và nhược điểm của việc phối hợp kháng sinh, để từ đó có định hướng điều trị phù hợp cho bản thân.
Xem thêm:
Dược sĩ Đại học Nguyễn Tuấn Trịnh
Từng làm ở Viện ISDS, nhiều năm cộng tác với CDC Thái Nguyên triển khai dự án phòng chống HIV/AIDS, 2 năm cộng tác với WHO.